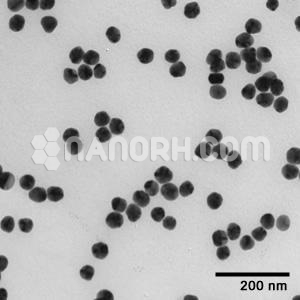
Silver (Ag) Nanopowder / Nanoparticles Water Dispersion Silver (Ag) Nanopowder / Nanoparticles Water Dispersion

Silver (Ag) Nanopowder / Nanoparticles Water Dispersion (Ag Aqueous Dispersion, 2 nm, 200ppm, Colorless and Transparent)
This product is a very stable complex silver solution with ultra-small nano-particles, has a very good anti-bacterial and anti-yellowing properties. The product is for research purpose! (To dilute it to your desired concentration, only add pure water and shake it up!)
| Silver (Ag) Nanopowder / Nanoparticles Water Dispersion | |
| Product No | NRE-22024 |
| CAS No. | 7440-22-4 |
| Formula | Ag |
| Molecular Weight | 107.868 g/mol |
| APS | <2nm (can be customized) |
| Purity | 99.9% |
| Color | Colorless and Transparent |
| Concentration | 200ppm |
| Solvent | Water (as per requirement) |
Silver (Ag) Nanopowder / Nanoparticles Water Dispersion
Silver nanopowder / nanoparticles water dispersion This product is a very stable complex silver solution with ultra-small nano-particles, has a very good anti-bacterial and anti-yellowing properties.
Features:
1. Broad-spectrum sterilization with long-lasting effect. 2. Rapid onset, no drug resistance. 3. Safety and environmental protection, easy to use.
Ag Aqueous Dispersion, Silver (Ag) Aqueous Dispersion, Ag Water Dispersion, Silver (Ag) Water Dispersion
Applications:
Various antibacterial finishing for textiles, paper products, leather, and the sponge; anti-bacterial deodorant treatment for all kinds of footwear, toys, and daily necessities; used to implement anti-bacterial deodorizing for a variety of water-based and oil-based paints; widely used in the medical field: microbicides, antibacterial gel, lotion, and tablets.
Antimicrobial and Medical Applications
Silver nanopowder / nanoparticles water dispersion are perhaps most well-known for their antibacterial, antiviral, and antifungal properties. When dispersed in water, these nanoparticles maintain their biocidal properties and are widely used in medical and healthcare applications.
Wound Care and Dressings: Ag-NPs in water dispersion are commonly used in wound dressings due to their ability to inhibit microbial growth. The antimicrobial activity of silver helps to prevent infection and accelerate the healing process. Silver-coated bandages or dressings can effectively treat chronic wounds, burns, and surgical wounds.
Surface Coatings for Medical Devices: Silver nanopowder / nanoparticles water dispersion dispersed in water are used as coatings for medical devices such as catheters, implants, and surgical tools. The silver coating prevents the growth of harmful bacteria and biofilms, reducing the risk of hospital-acquired infections (HAIs), which are a significant concern in healthcare settings.
Antimicrobial Water Treatment: Ag-NPs in water dispersion can be used to treat drinking water and wastewater. Their ability to kill a broad spectrum of pathogens, including bacteria and viruses, makes them an effective tool in water disinfection. Silver nanoparticles can be used in filters, water purifiers, and bottled water systems to improve water quality.
Drug Delivery Systems: Silver nanoparticles are used in drug delivery systems, where their ability to bind with specific biomolecules enables targeted drug release. The dispersion in water helps to stabilize the nanoparticles and make them suitable for in vivo applications, particularly in cancer treatment or antibiotic delivery.